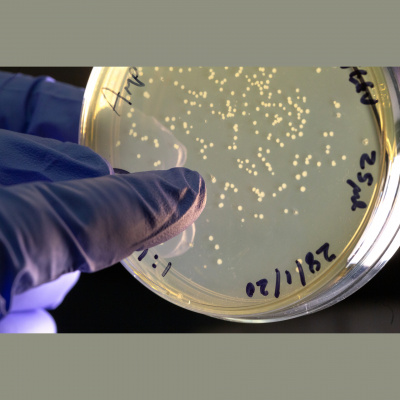
Imperial College Podcast

Imperial College Podcast
Podcast: COVID-19 vaccine development, patient data and isolation diaries
- Autor: Vários
- Narrador: Vários
- Editor: Podcast
- Duración: 0:24:31
- Mas informaciones
Informações:
Sinopsis
In this edition: We hear from researchers working on a COVID-19 vaccine and with patient samples, and how students are coping in isolation. News: University Challenge win and neutrino discovery – We celebrate Imperial’s spectacular University Challenge win and discover how neutrinos may hold the key to why the universe is made up of matter rather than antimatter. On the frontlines of COVID-19 vaccine development – We speak to Dr Anna Blakney about what it’s like to work on a vaccine the whole world is waiting for. This feature is an excerpt from 'Never Lick the Spoon' – a monthly podcast from Imperial's Institute for Molecular Science and Engineering. Understanding and treating COVID-19 – We hear from Professor Peter Openshaw how thousands of samples from COVID-19 patients across the country are already providing valuable insights into the disease, including who seems to get it worse, and how the disease progresses. Isolation diaries from around the world – We hear from the producers of a video capturing